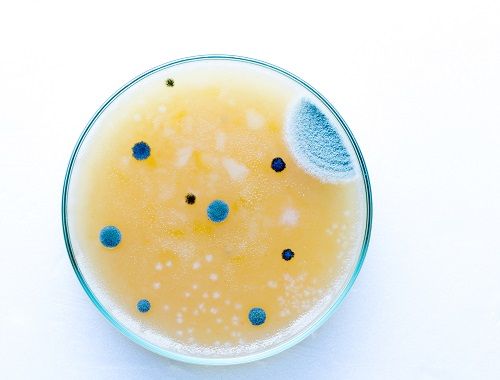

Antibiotics
Latest News
Latest Videos

CME Content
More News

Alan Gross, PharmD, shares the drawbacks of some of the current prediction tools used for pneumonia.

WHO report confirms that “the world is running out of antibiotics” to treat resistant priority pathogens

As practitioners continue to mistake the worsening of asthma symptoms for bacterial respiratory infections, more antibiotics are being prescribed, many times, inappropriately.

Daniel Pilch, PhD, explains how the health care system must change in order to battle antibiotic resistance.

Antimicrobial stewardship and antimicrobial susceptibility testing (AST) remain critical in the race against antimicrobial resistance.

Alan Gross, PharmD, shares how an early diagnosis of multidrug-resistant pneumonia can work towards improving patient outcomes.

Meghan Jeffres, PharmD, shares what should be considered when considering the incorporation of penicillin skin testing into a health care facility.

Diagnostic methods make all the difference in efforts against antimicrobial resistance.

Edmond LaVoie, PhD, shares different approaches that can be used to forestall the development of antibiotic resistance.

Alan Gross, PharmD, BCPS-AQID, shares how the Society of Infectious Diseases Pharmacists is working to improve antibiotic stewardship programs in long-term care facilities.

To paraphrase Anthelme Brillat-Savarin, “we are what we eat”—Especially when it comes to antimicrobials and food-producing animals.

Jason Pogue, PharmD, BCPS-ID, explains the clinical significance of his research team’s findings regarding the use of ceftolozane-tazobactam to treat Pseudomonas infections.

Edmond LaVoie, PhD, explains how his team’s approach can be applied in the development of novel drugs for the treatment of drug-resistant infections caused by Gram-negative and Gram-positive bacteria.

A team of researchers discover that Klebsiella pneumoniae is not the only culprit behind life-threatening healthcare-associated infections: there are two other Klebsiella species that share the blame.

Lucy B. Palmer, MD, from Stony Brook University School of Medicine in New York argues that inhaled antibiotic therapy provides higher drug concentrations of antibiotics with fewer systemic side effects than IV therapy.

The results of a new study from Vanderbilt University provide more support for breastfeeding, revealing that sugars in human breast milk can help protect babies from bacterial infections.

Daniel Pilch, PhD, discusses the approach that he and his team took to develop a new drug to fight MRSA.

A herpes infection leads to deadly viral meningitis in an Iowa infant, an ingestible smart pill that can remind you to take your medications, global catastrophic biological risks, whether or not you should complete the full course of antibiotics, and all you need to know about Candida auris make up this week’s Top 5 articles.

Milena McLaughlin, PharmD, MSc, explains how antimicrobial shortages differ between high- and low-income countries.

Reports of increasing cases of antibiotic-resistant gonorrhea are on the rise and in fact, the World Health Organization has designated the infection as high priority as it poses a great public health threat.

Daniel Pilch, PhD, discusses the potential of Staphylococcus aureus to develop resistance to TXA709.

Reducing overall antibiotic exposure is likely to have an impact on decreasing antimicrobial resistance.

Jason C. Gallagher, PharmD, addresses the undetermined importance of fixed antibiotic durations.

This training will empower pharmacists practicing in LTC facilities to develop antimicrobial stewardship programs, improve patient outcomes related to infectious diseases, and facilitate compliance with CMS requirements.

An ingestible smart pill developed by Proteus Digital Health can remind patients with chronic diseases to take their medication.